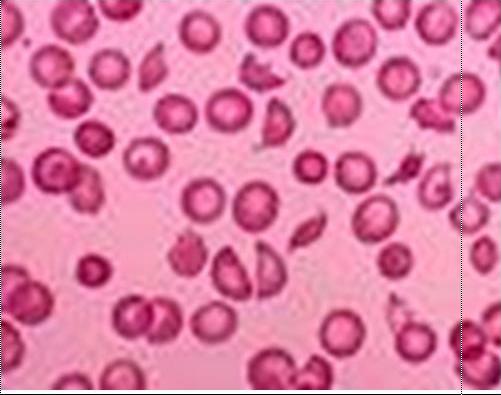

Ukuran normal margin, ukuran normal poster, ukuran normal truk cng, ukuran normal foto dalam inchi, ukuran normal sapi bali betina, ukuran normal kornea dan lensa mata manusia,





Random Image

Ukuran normal margin, ukuran normal poster, ukuran normal truk cng, ukuran normal foto dalam inchi, ukuran normal sapi bali betina, ukuran normal kornea dan lensa mata manusia,